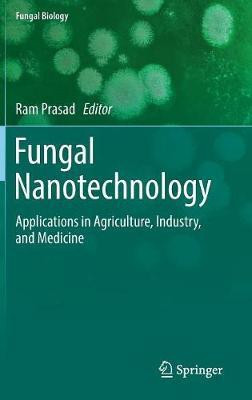

Fungal Nanotechnology(English, Hardcover, unknown)
Quick Overview
Product Price Comparison
Fungal nanotechnology has great prospects for developing new products with industrial, agricultural, medicinal, and consumer applications in a wide range of sectors. The fields of chemical engineering, agri-food, biochemistry, pharmaceuticals, diagnostics, and medical device development all employ fungal products, with fungal nanomaterials currently used in applications ranging from drug development to the food industry and agricultural biotechnology. Fungal agents are an environmentally friendly, clean, non-toxic agent for the synthesis of metal nanoparticles and employ both intracellular and extracellular methods. The simplicity of scaling up and downstream processing and the presence of fungal mycelia which afford an increased surface area provide key advantages. In addition, the large spectrum of synthesized nanoparticle morphologies and the substantially faster biosynthesis rate in cell-free filtrate (due to the higher amount of proteins secreted in fungi) make this a particularlyenticing route. Understanding the diversity of fungi in assorted ecosystems, as well as their interactions with other microorganisms, animals, and plants, underpins real and innovative technological developments and the applications of metal nanoparticles in many disciplines including agriculture, catalysis, and biomedical biosensors. Importantly, biogenic fungal nanoparticles show significant synergistic characteristics when combined with antibiotics and fungicides to offer substantially greater resistance to microbial growth and applications in nanomedicine ranging from topical ointments and bandages for wound healing to coated stents.